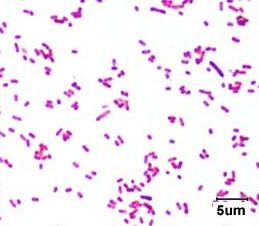

Category Weird facts
How long would it take for E. coli to outweigh the universe?
Escherichia coli reproduces every 20 minutes when nutrients are plentiful.
How many of your “cells” are actually of human origin?
The normal adult human body is composed of approximately 10^13 cells.
What is the most abundant organism on Earth? Not what you’d think!
Tailed phages are a kind of bacteriophage— viruses that infect bacteria. They are the most abundant organism on Earth, with an estimated 10^31 particles in our biosphere.